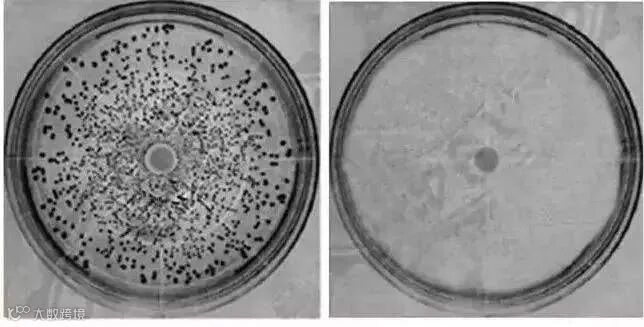

其实他是有口臭问题
只是之前没戴口罩感觉不到
现在天天戴口罩办公
自己都受不了这种气味
口臭确实是一个非常糟糕的问题
特别是现在天天戴口罩
也终于意识到
自己的“味道”是多么严重
 你是不是也有这样的经历
你是不是也有这样的经历

有口气确实是很令人尴尬的
未见其人先闻其味的痛苦
尤其是在日常交际中
对形象分大打折扣
要是自己是口臭本人
就更加难堪了!
畅由粉丝专享
铁皮石斛牙膏 用“仙草”制成的牙膏
去烟渍、茶渍、咖啡渍
恢复珍珠亮白,温和草本植物
清新口气!改善口腔健康!
粉丝特惠 25元/支




而且口臭不仅是表面问题
获2005年诺贝尔医学奖的
马歇尔研究发现
引发口臭的元凶是一种特殊的细菌
幽门螺旋杆菌(简称HP)

可能你还不知道它是什么?
幽门螺杆菌是目前
发现唯一能在胃里活着的细菌
它从口腔进入胃部后
会水解出一层氨“保护罩”
来免受胃酸的侵蚀!
这种臭鸡蛋味儿的氨臭,就是口臭的来源!

更可怕的是
不干净的口腔简直就是细菌的温床
病菌不断迅速繁衍
不但会侵蚀牙齿,还会进入你的肠胃
引起肠胃炎、肠胃溃疡,腹泻,甚至于胃癌!

通常有口臭问题,牙齿也会发黄!
那种不能说话又不能笑的痛苦
真的是没朋友了!
为什么天天刷两次牙
而且吃完东西用水漱口
牙齿还是特别黄
而且还有一层黄黄的东西附着在表面
真的特别恶心!

这些口腔问题
总的来说就是洁牙不彻底导致
口腔内的食物残渣
会容易滋生大量细菌
从而产生口臭,并形成牙菌斑、黄色牙垢

所以你不仅需要一支好的牙刷
牙膏的选择也是尤为关键的!
今天小编给推荐这款
铁皮石斛草本牙膏
铁皮石斛可以灭杀幽门螺旋杆菌
从根源去除口臭!
而珍珠贝和植酸钠可以清洁牙渍
白芨提取物能有效缓解炎症

可能有很多人不知道铁皮石斛是什么?
铁皮石斛是非常珍贵的中草药
其在民间有着“仙草”的美誉
它有滋养阴津、增强体质、补益脾胃
护肝利胆、强筋降脂等作用

也被现代多项医学研究证明
有助于缓解萎缩性胃炎、浅表性胃炎
对幽门螺杆菌有显著抑制作用
同事用了一段时间
现在带上口罩也没那么臭了
而且多年的黄牙也刷白了

小编也亲身试验过一段时间
原本的黄牙竟然真的亮白了不少
而且每次用完口气都特别清新

01
强效灭杀幽门螺旋杆菌、除口臭
世界卫生组织也已经把口气
作为一种病来进行报道
在中国,口气发病率高达27.5%
也就是说,平均每4个人就有1个人就有口气!
而且有口臭是非常尴尬的事情
先不说日常交际
光是和伴侣之间有亲密接触都会被嫌弃
非常影响彼此的关系

而口臭根源是幽门螺旋杆菌
铁皮石斛草本牙膏采用独家抗菌配方
能够灭杀幽门螺旋杆菌
从根源上缓解口臭
铁皮石斛是一种名贵中药材
药用价值超过天山雪莲、人参、冬虫夏草
被誉为“中华九大仙草之首”!

用它刷牙石斛的精华被
口腔粘膜吸收
从源头上杀灭幽门螺旋杆菌
不管是附着在牙齿表面的
食物残渣、斑菌
还是牙齿缝隙,牙龈深处、口腔粘膜
中的幽门螺旋杆菌
都能360°全口腔无死角的消灭干净!

为了检验石斛牙膏和其他牙膏对比
小编专门做了试验
可以看出石斛牙膏对
幽门螺旋杆菌的抑制作用非常强
 右边为石斛牙膏
右边为石斛牙膏
口腔内细菌被杀灭
口腔自然健康
顽固的口臭也得到缓解
不用担心口臭带来的尴尬
畅由粉丝专享
铁皮石斛牙膏 用“仙草”制成的牙膏
去烟渍、茶渍、咖啡渍
恢复珍珠亮白,温和草本植物
清新口气!改善口腔健康!
粉丝特惠 25元/支



02
清除牙垢,告别尴尬黄牙
由于现在都市人不良饮食习惯
在饮食和口腔清洁方面没有过多注意
牙渍、烟渍、茶渍堆积
长此以往就会形成
黄牙、牙垢、牙结石等问题!

这就是为什么你天天刷牙
牙齿还是会发黄了
而这款石斛牙膏
蕴含多种洁牙有效成分
能有效清除牙齿表面的污渍

铁皮石斛牙膏中含有
珍珠贝、植酸钠和水合硅石
这些都是国际公认
高端纯天然美白成分!

有效去除烟渍、茶渍、咖啡渍、牙菌斑、黑黄色素
从源头抑制口腔细菌!

市场上很多牙膏为了增强去渍效果
而加入大量的碳酸钙
但长久使用会损伤牙釉质
而铁皮石斛牙膏应用了微米技术
微米级别的分子
能够渗透进牙齿表面和牙缝中
快速溶解牙齿污垢和牙菌斑
还不会对牙齿造成损伤

用了这款石斛药膏
给你的口腔温和清洁
采用天然成分改善口腔环境之余
也不会伤害牙齿牙龈!

03
抑菌止痛,缓解口腔问题
除了口臭和黄牙外
还有一个口腔问题是非常痛苦
那就是口腔溃疡
虽然口腔溃疡不是什么大病
可疼起来却是要人命!

白芨具有抗溃疡的作用
具有高度的粘性
能促使溃疡面愈合
再加上白芨中含有的有益成分
对于细菌有抑制作用

使用一段时间后
明显感受到炎症慢慢消退
当细菌不再滋生
炎症、红肿就可以得到抑制
口腔溃疡的疮口就会越来越小

同时白芨中的多种聚糖
有缓解牙龈敏感、出血的功效
刷牙易出血的人
建议坚持使用石斛牙膏
用几次后能感受到明显改善了

由于饮食不规律
小编嘴巴的溃疡反反复复
但坚持用了这款牙膏后
感觉溃疡复发频率不再频繁
一定要坚持使用!

不仅小编种草这款产品
更有众多粉丝和使用者推荐这款!

04
健康不含氟,方便快捷
市面上的很多牙膏都添加了氟元素
而氟的过度摄入会导致牙齿变色
这款牙膏与市面上
为了达到清洁效果相比
它是不含氟、不会伤害到牙龈、牙齿
可以放心使用!

为什么要选用不含氟的牙膏呢?
因为小朋友容易误吞牙膏泡沫
会导致体内氟含量过高
影响智力的发育


不管在牙齿表面的菌斑和残留物
还是牙齿缝隙、死角中的细菌
能迅速清理干净
还不会对牙齿造成损伤
用石斛牙膏一段时间
你会发现自己的牙龈越来越好
各种冷热酸甜想吃就吃
再也不怕口腔出问题!

还有权威质检的认证
安全有保证!

能温柔的呵护牙龈、牙齿
有效改善多种口腔问题
让你恢复亮白牙齿、健康口腔
自信的笑容会让一切瞬间成为陪衬
唇红齿白才是小仙女们应该有的样子!

粉丝福利大放送!
铁皮石斛草本牙膏
厂商指导价58元一支
现给粉丝福利,只需25元!
库存有限,售完即止哦!
▼▼▼
畅由粉丝专享
铁皮石斛牙膏 用“仙草”制成的牙膏
去烟渍、茶渍、咖啡渍
恢复珍珠亮白,温和草本植物
清新口气!改善口腔健康!
粉丝特惠 25元/支







